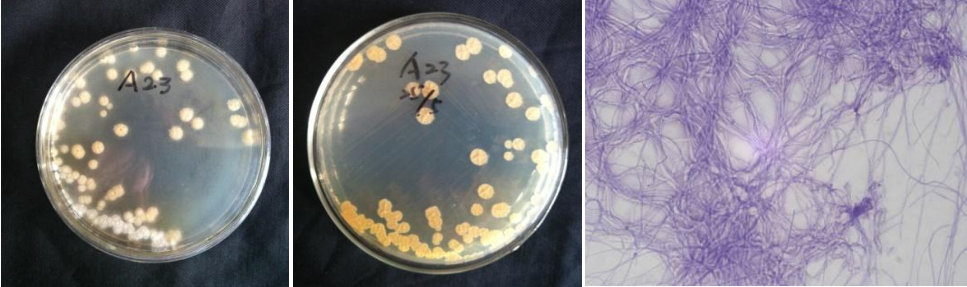

Loading...
| StrainNO | A23 |
| Classification | Streptomyces |
| 16s rDNA sequence | ATTGAGACGACAGCCTCATGCACCACCTGTACACCGACCACAAGGGGGCGACCATCTCTGGCCGTTTCCGGTGTATGTCAAGCCT TGGTAAGGTTCTTCGCGTTGCGTCGAATTAAGCCACATGCTCCGCTGCTTGTGCGGGCCCCCGTCAATTCCTTTGAGTTTTAGCC TTGCGGCCGTACTCCCCAGGCGGGGAACTTAATGCGTTAGCTGCGGCACCGACGACGTGGAATGTCGCCAACACCTAGTTCCCAA CGTTTACGGCGTGGACTACCAGGGTATCTAATCCTGTTCGCTCCCCACGCTTTCGCTCCTCAGCGTCAGTAATGGCCCAGAGATC CGCCTTCGCCACCGGTGTTCCTCCTGATATCTGCGCATTTCACCGCTACACCAGGAATTCCGATCTCCCCTACCACACTCTAGCC TGCCCGTATCGAATGCAGACCCGGGGTTAAGCCCCGGGCTTTCACATCCGACGCGACAAGCCGCCTACGAGCTCTTTACGCCCAA TAATTCCGGACAACGCTTGCGCCCTACGTATTACCGCGGCTGCTGGCACGTAGTTAGCCGGCGCTTCTTCTGCAGGTACCGTCAC TTTCGCTTCTTCCCTGCTGAAAGAGGTTTACAACCCGAAGGCCGTCATCCCTCACGCGGCGTCGCTGCATCA |
| Strain Morphology Photos | |
| Morphological Description | Hypha branch;septum;not fracture;protoplasm began to agglomerate spore chain straight long spore pile white;few;back bean juice yellow |